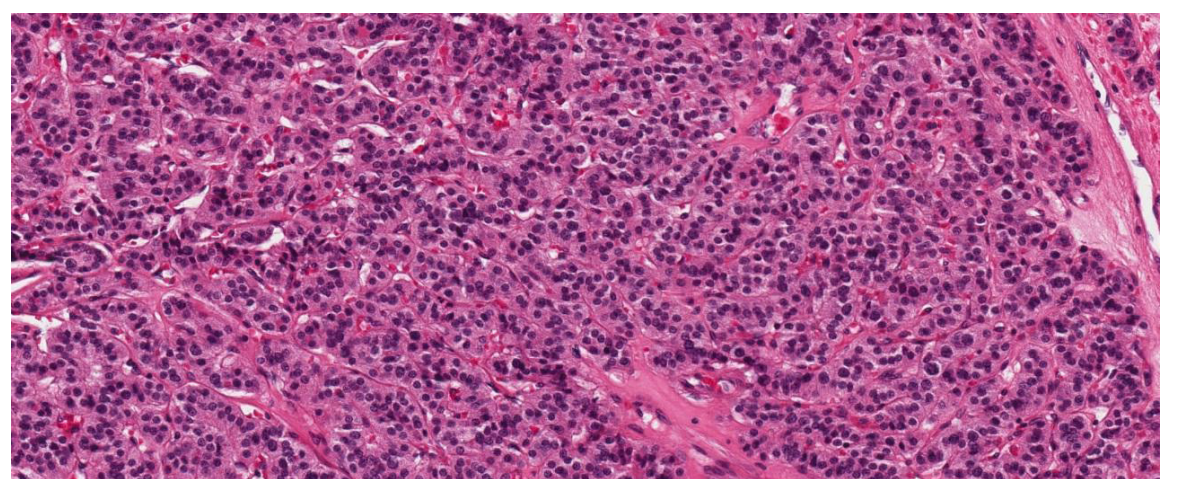

Статья размещена в открытом доступе и распространяется на условиях лицензии Creative Commons Attribution (CC BY).
КЛИНИЧЕСКИЙ СЛУЧАЙ
Морфологический, иммуногистохимический и молекулярный анализ дифференцированной высокозлокачественной карциномы
Российский национальный исследовательский медицинский университет имени Н. И. Пирогова, Москва, Россия
Для корреспонденции: Далгат Рамазанович Махачев
ул. Академика Волгина, д. 37, г. Москва, 117437, Россия; ur.liam@2002taglad
Вклад авторов: Д. Р. Махачев, Д. В. Буланов, М. М. Шовхалов, Б. З. Бекмурзиев, И. А. Героев — анализ и интерпретация данных, написание текста статьи, редактирование; А. М. Нецветова, А. Р. Жусупова — написание текста статьи, редактирование; Д. С. Губич, А. М. Мановски — сбор клинических данных, редактирование.